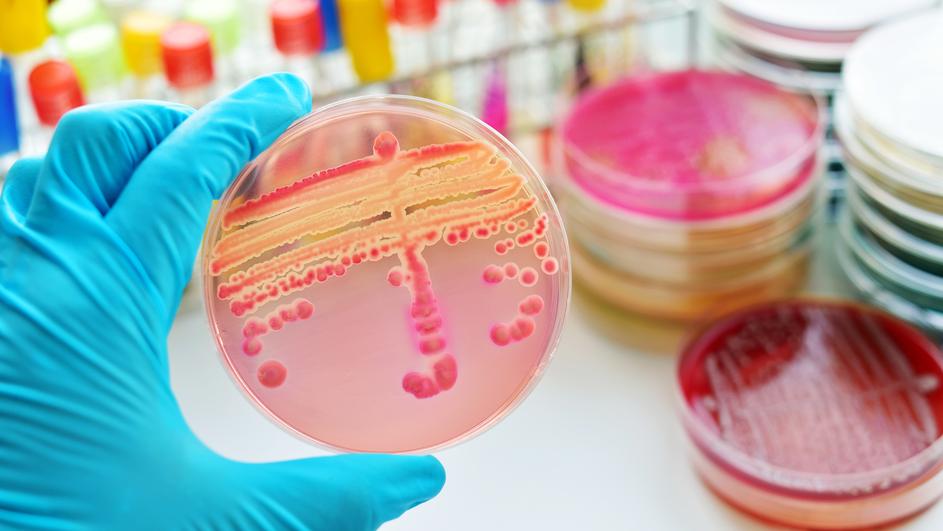
antibiotik otporan

Novi antibiotik puno je jači od svega što postoji danas na tržištu, uništio je 20-ak bakterija, i stafilokoke i streptokoke uključujući i šarlah kod miševa. Otkrili su ga u talijanskom tlu.
Novi antibiotik puno je jači od svega što postoji danas na tržištu, uništio je 20-ak bakterija, i stafilokoke i streptokoke uključujući i šarlah kod miševa. Otkrili su ga u talijanskom tlu.
Znanstvenici su u uzorku tla uzetog u Italiji otkrili novi antibiotik koji djeluje na bakterije otporne na poznate antimikrobne lijekove. Ovaj novi antibiotik koji proizvodi jedna vrsta mikroba, nazvan je “pseudouridimicin” (PUM).
On je u laboratorijskim ispitivanjima uništio čitav niz bakterija, među kojima i veći broj rezistentnih. Usto je uspio izliječiti šarlah kod miševa.
Pseudouridimicin neutralizira enzim koji ima važnu ulogu u gotovo svim funkcijama svih organizama, polimerazu. No njegov mehanizam se razlikuje od mehanizma rifampicina, antibiotika koji također cilja isti enzim. Tako kod ovog novog antimikrobnog sredstva postoji deset puta manji rizik stvaranja otpornosti na antibiotike, nego kod lijekova koji su trenutačno na tržištu.

PUM je u laboratoriju ubio dvadeset vrsta bakterija, a pokazao se djelotvoran i protiv streptokoka i stafilokoka, od kojih su neki otporni na više vrsta antibiotika.
Klinička ispitivanja s ovim novim antibiotikom mogla bi početi za tri godine, a na tržištu bi se mogao pojaviti za desetak, rekli su istraživači sveučilišta Rutgers – New Brunswick i talijanske biotehnološke tvrtke Naicons.
Ovo otkriće još je jedan dokaz da su bakterije iz zemlje najbolji izvor novih antibiotika, zaključili su znanstvenici. piše






























